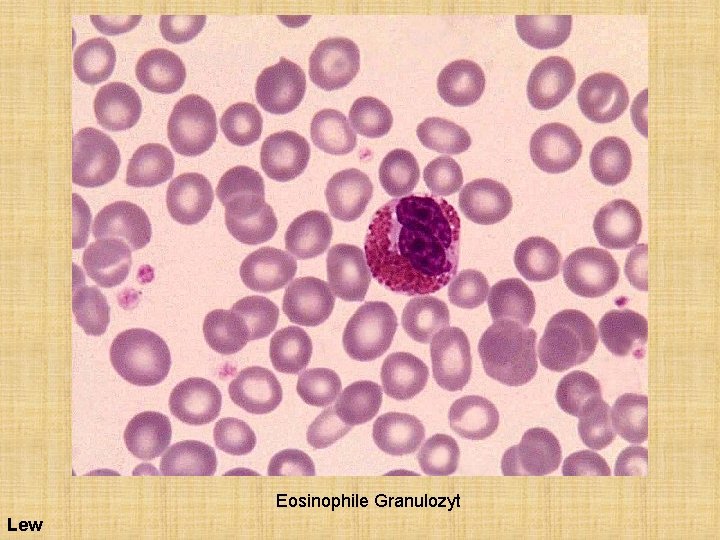
Eosinophile Granulozyt Lew
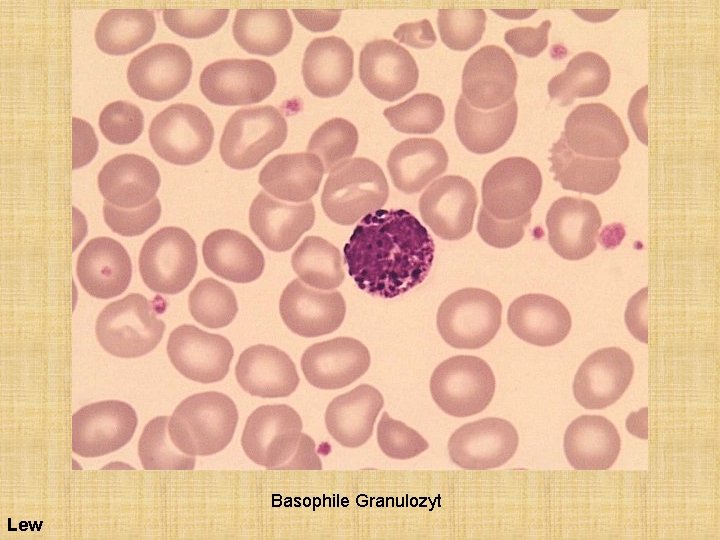
Basophile Granulozyt Lew
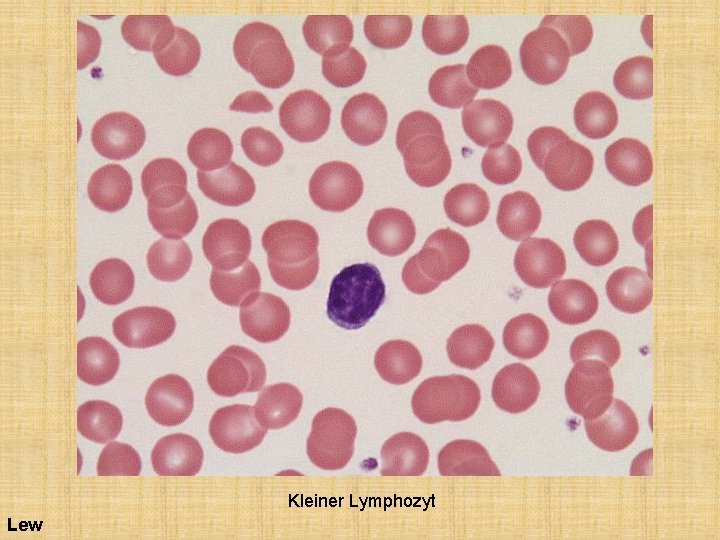
Kleiner Lymphozyt Lew

Blut und Blutzellen 2018 Dr Attila Magyar 31

Blut und Blutzellen 2018 Dr. Attila Magyar 31. 10. 2018

Blutplasma Buffy coat (Leukozyten) Erythrozyten

Blut besteht aus den Blutzellen und der gerinnungsfähigen, flüssigen Blutplasma. Den Anteil, den die Blutzellen am Blutvolumen einnehmen, bezeichnet man als Hämatokrit (40 -60%).

Blutzellen • Rote Blutzellen (Erythrozyten) • Weiße Blutzellen (Leukozyten) • Blutplättchen (Thrombozyten)

Die Zahl der Blutzellen • In 1 mm 3 (1 ml) Blut findet man: 4 -6 x 106 Erythrozyten 2 -4 x 105 Thrombozyten 4 -10 x 104 Leukozyten • in SI: alles geht als „pro liter Blut”… x 1012/l Ery, x 109/l Leu, x 1010/l Thr

Herstellung des Blutausstrichs. Für Routineuntersuchung werden Farbmischungen verwendet, die alle auf die Romanowsky Färbung zurückgehen: sie braucht eine Mischung von Methylenblau und Eosin.

Cornell

Färbungen • May-Grünwald (ohne Azur) • Giemsa (mit Azur) • Pappenheim: eine Kombination von May-Grünwald und Giemsa (deswegen wird oft als MGG verkürzt). • 4 Färbungseigenschaften lassen sich unterscheiden: • Basophilie (blau): Bindung der Methylenblau • Azurophilie (rötlich): Affinität zu Azur • Azidophilie (Eosinophilie) (gelblich-röt): Affinität zu Eosin • Neutrophilie (lachsfarben bis lila): lila) Affinität zu einem Farbstoffkomplex, der in der Mischung entsteht.

Ergebnisse der MGG-Färbung • • Zellkerne: rötlich-violett Zytoplasma der Erythrozyten: rosa Zytoplasma der Lymphozyten: hell blau Zytoplasma der Monozyten: grau-blau eosinophile Granula: ziegelrot bis orange basophile Granula: dunkel violett neutrophile Granula: hell violett

Prozentuelle Verteilung der Leukozyten • NEU>LY Polymorphonukleäre Zellen oder Granulozyten neutrophile (50 -85%), eosinophile (0 -20%) und basophile (0 -3%) Granulozyten Mononukleäre Zellen: Lymphozyten (10 -40%) Monozyten (0 -10%)

Erythrozyten

Die Erythrozyten I. • Bikonkave Scheiben mit einem Durchmesser von 7 μm (Normozyt) • Keine Granulation, kein Kern • Rosa oder graues Zytoplasma • 0, 1 -1% der Erythrozyten enthält lila zytoplasmatischen Körnchen: Retikulozyten (Ribosomen) • 30% ihrer Proteine: Hämoglobin • Lebensdauer: 120 Tage.

Die Erythrozyten II. • Funktionen: Gastransport (O 2, CO 2, N 2) • Entfernung der Immunkomplexen aus Blutstrom durch CR 1 Komplementrezeptoren (in der roten Pulp der Milz werden diese Komplexen durch Makrophagen entfernt, die Erythrozyten können dann in die Blutzirkulation zurückkehren.

Erythrozyten (500 x: links, 1000 x: unten) Die kleine basophile Pünktchen sind Thrombozyten Lew

Alb Rho

Oben: Erythrozyten (1) umgegeben von Zellmembran (3). Zytoplasma erscheint als dunkle Masse (wegen Hämoglobininhalt). Thrombozyt (5). Unten: Retikulozyt (noch nicht vollgereifte Erythrozyt) mit Mitochondrium (linkes und rechtes Bild: 1), Siderosome (Eisenspeicherkörnchen; links: 4, rechts: 2), Rest von Golgi (links: 3) und Polyribosom (rechts 4) Rho

Howell-Jolly Körper (Rest des Zellkerns) beim Pfeil

MHC I Zellmembranproteine Ausstoß des Erythrozytenkerns und das Verloren der MHC I Molekülen aus der Zellmembran

Assymmetrische Zusammensetzung (von Phospholipiden) des Blutzellmembrans Alb

Neutrophile Granulozyten

Neutrophil Granulozyten • Durchmesser: 12 -15 μm. • Rundovale Zellen mit rosa Zytoplasma. • Kern: heterochromatisch, 2 -5 Segmenten (reife Neutrophilen) oder gekrümmt (Jugend oder Stab) • Primäre (azurophile) und sekundär (spezifische) Granula

Neutrophilen II. • Azurophile Granula (rötlich): wenigere, größere (0, 5 -1 mm) Körnchen; sie enthalten lysosomale Enzymen, Myeloperoxidase; sie werden mit Phagosom fusioniert. • Spezifische Granula: (hellrosa), viele, kleinere (0, 3 -0, 8 mm) Körnchen; sie enthalten bakterizide Proteine (Defensins, Lactoferrin); sie werden durch Exozytose (Degranulation) abgegeben.

Neutrophilen III. • Sehr wichtig sing in der unspezifischen Abwehrreaktionen des Körpers. • Halbwertszeit in Blut: 10 -15 St. • Aktive Migration auf den Stellen der Invasion von Mikroorganismen (Chemotaxis) • Phagozytose von Mikororganismen: Microphagen • Abtöten der Mikororganismen duch Myeloperoxidase (H 2 O 2, O 2 -, OCl-)

Lew Neutrophile Granulozyte (Segment)

Lew Neutrophile Granulozyte (Segment)

Neutrophil mit azurophil (5) und spezifische (6) Granula. Rho

Aspezifische (azurophile; 1) und spezifische (2) Granula der Neutrophilen. Granulum nach Degranulation (3). Glykogen (4). Rho


Lew Zwei stabkernige (einfache Name: Stab oder Band) und ein segmentkernige Neutrophilen

Jugend (Mitte, gelber Pfeil), Stab (links) und Segment (rechts) auf einen Lew Schlag! (Drei Neutrophilen)

Eosinophile Granulozyten

Eosinophil Granulozyten I. • Durchmesser ist 10 -15 μm. • Zellkern doppel gelappt, heterochromatisch. • Eosinophile (gelblich-rote) Granula • Lebensdauer 10 Tagen in Blut. • Es gibt nur einen Granulatyp (sie sind modifizierte Lysosomen): 0, 5 -1 μm. • Die Granula often enthalten Kristalloid (Internum).

Eosinophil Granulozyten II. • Sie sind zur amöboiden Bewegung und zur Phagozytose befähigt. • Bei Parasitosen und Allergie kommt es zu einer Zunahme der Eosinophilen im Blut. Degranulation kommt vor bei der Anerkennung der mit Antikörpermolekülen bedeckten (opsonierten) Parasiten. • Eosinophile können die allergische Reaktionen unterdrücken.

Eosinophil Granulozyten III. • die eosinophilen Granula enthalten: MBP (major basic protein)(antiparasitisch), EDN (eosinophil-derived neurotoxin; antiparasitisch), EPO (eosinophil peroxidase; bakterizid), ECP (eosinophil cationic protein; Antikoagulant)
Eosinophile Granulozyt Lew

OL

Eosinophiler granulozyt im TEM Aufnahme Spezifische (eosinophile) Granulen enthalten Krystalloid Kristalloid Rho

Basophile Granulozyten

Basophile Granulozyten • 10 -12 μm (die kleinsten Granulozyten) • Kern: oval oder bohnenförmig. • Viele basophile Granula (0, 5 -1, 5 μm), die sich dunkellila färben. • Die Granulen enthalten Heparin und Histamine. • Degranulation (wie bei den Mastzellen) leitet zur allergischen Reaktionen. • Degranulation wird durch das Allergen gelöst mit hilfe von an der Zellmembran gebundenen Ig. E
Basophile Granulozyt Lew

OL

Rho

Lymphozyten

Lymphozyten • Durchmesser: 6 -8 μm (kleine Ly), 9 -15 μm (grosse Ly). • Grosser, runder Kern, heterochromatisch • Der sehr schmale Zytoplasmasaum ist blau. • Immunabwehr. • NK-Zellen erscheinen im Blut als Large Granular Lymphocyten (LGL Zellen) mit einigen azurophilen Granula.
Kleiner Lymphozyt Lew

Kleiner Lymphozyt OL Großer Lymphozyt

Monozyten

Monozyten I. • 15 -25 μm, unregelmäßige Zellen • Kern: unregelmäßig (oval, U oder Nierenförmig), exzentrisch • Zytoplasma: grau-blau mit wenigen azurophil Granula (Lysosomen) • Halbwertszeit im Blut 12 -100 St, dann wandern sie mit amöboider Bewegung in die Gewebe (hier können sie 2 -3 Monate leben).

Monozyten II. • Phagozytose: Makrophagen (Mikroorganismen, apoptotische, nekrotische Zellen) • Opsonisation (Antikörper bedeckte Mikororganismen sind schneller phagozytisiert) • Antigen presenting cells (APC)

Lew Monozyt

Vier Monozyten (unten rechts, die obere Zelle ist ein segmentkerniger Neutrophil für Vergleich: ) Lew

Monozyt im TEM Aufnahme mit azurophilen Körnchen (Granula): Lysosomen Rho

In allen Tierarten: sehr variabel: einzige Orientierungpunkt e: sie sind größer als die andere Zelltypen und Zytoplasma ist blaulich (often die Zellen ähneln an Granulozyten oder Lymphozyten) Cornell

Thrombozyten

Thrombozyten I. • 2 -4 μm, rundovale Strukturen • Ohne Zellkern • Sie entstehen durch Abschnürungen des Zytoplasma der Megakaryozyten im Knochenmark. • Lebensdauer in Blutstrom: 8 Tage. • Blauliches Zytoplasma enthaltet lila Granula (vorwiegend in der Mitte). • Hyalomer: peripherelle, helle Zytoplasmaregion • Granulomer: zentrale, granulenreiches Region.

Thrombozyten II. • Hyalomer: Randständige Mikrotubuli, Kanälchensystem (Tubuli und Bläschen) • Granulomer: a-Granula (0, 3 -0, 5 mm; Fibrinogen, PDGF); d-Granula (0, 25 -0, 3 mm; Serotonin, Ca. Ionen); l-Granula (Lysosomen) • Blutgerinnung: Serotonin (vasokonstriktion), Thrombozytenaggregation (Thrombozytenpropf; Aktin Zytoskeletonumordnung), Memebrane Phospholipide: Blutgerinnungskaskade, Fibrinogen: auch.

Lew Die Thrombozyten sind die kleine, basophile Strukturen mit ungefähr 1 mm Durchmesser zwischen die Erythrozyten (rote Pfeilen). Gut sichtbar sind das mehr lila Granulomer und das blauische Hyalomer.

Fettzelle Rö Thrombozytopese in roten Knochenmark. Die Vorläuferzelle, die Megakaryozyt ist eine riesengrosse, polyploide Zelle zwischen den 2025 mm grossen diploiden Blutbildende Zellen.


a-Granula: 6 a-Granules: 3, d-Granules: 4 Rho


Echynozyten Wasser Häufigste Artefakten Farbstoff-Niederschlag verschmierte Zellen Cornell
- Slides: 62